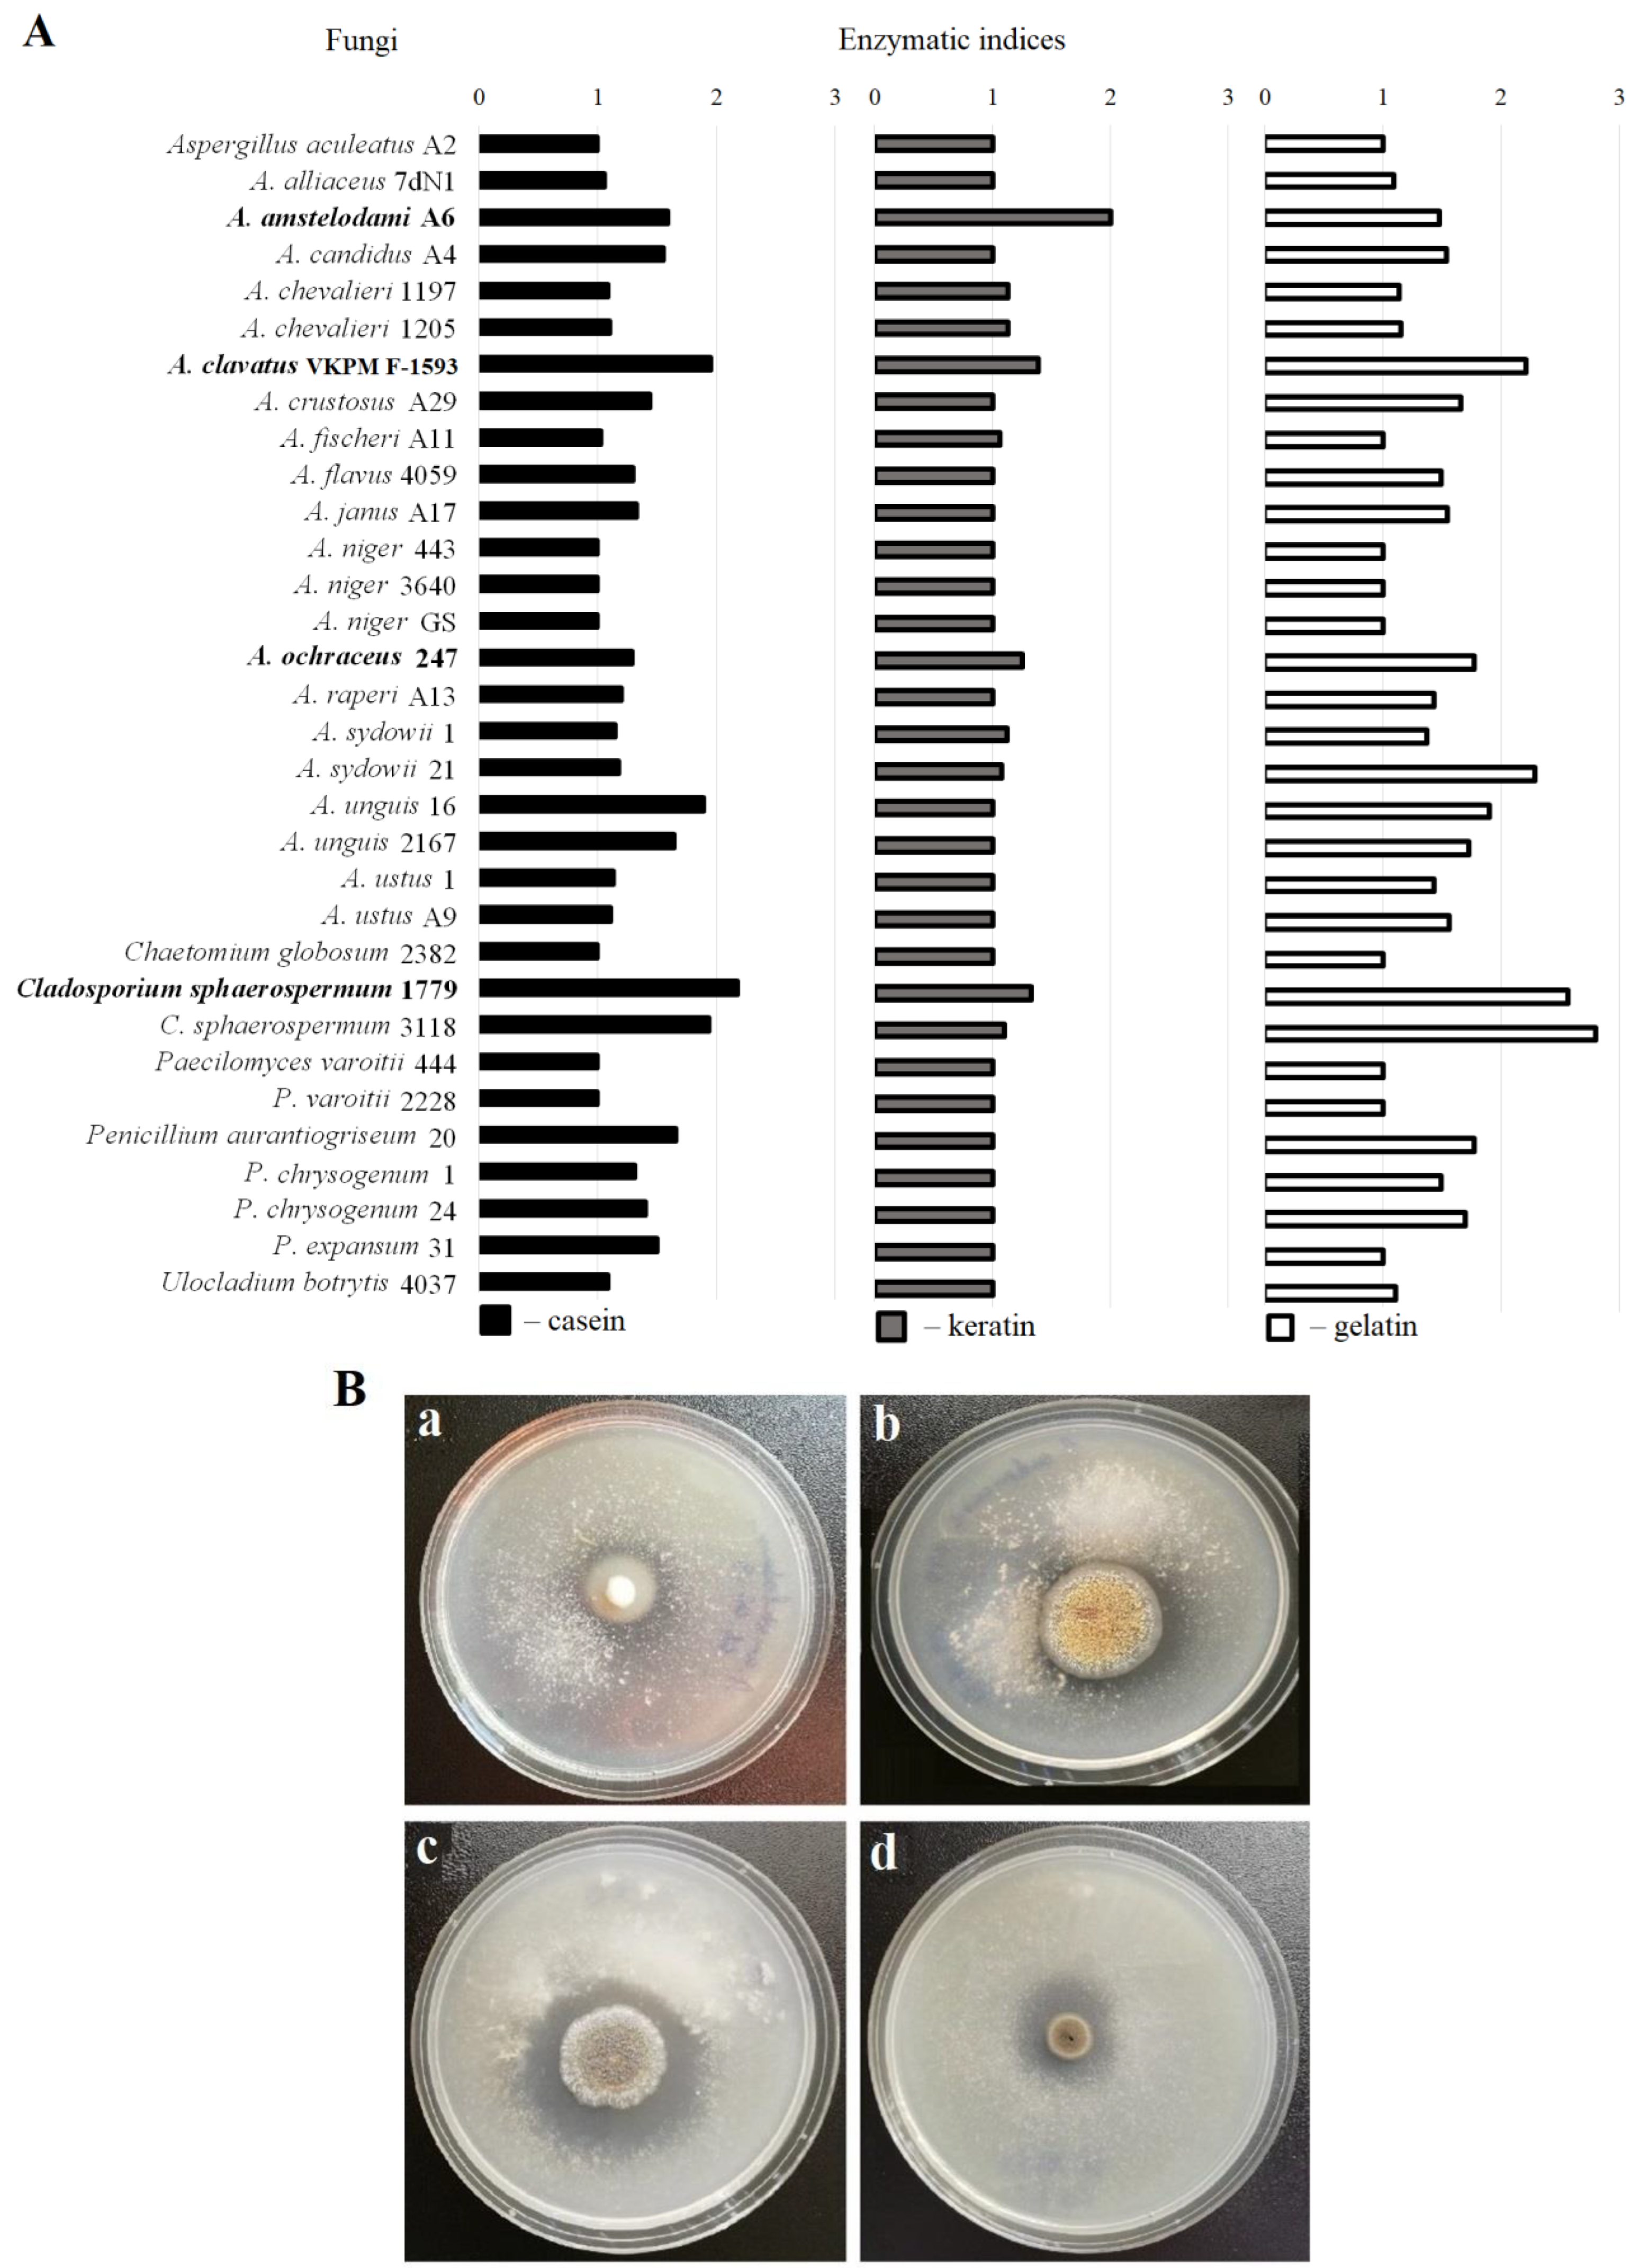
Ijerph 19 13939 g001

Keratinolytic Properties of Aspergillus clavatus Promising for Biodegradation
Abstract
1. Introduction
2. Materials and Methods
2.1. Materials
2.2. Storage of the Microorganisms
2.3. Fungal Strain Screening for the Ability to Secrete Keratinolytic Enzymes
2.4. Enzyme Production Optimization
2.5. Enzyme Activity Assay
2.6. Enzyme Isolation
2.7. Detection of Enzyme Glycosylation
2.8. Effects of Protease Inhibitors on Enzyme Activity
2.9. Effects of pH and Temperature on Enzyme Activity
3. Results
3.1. Screening for Fungi That Efficiently Produce Keratinolytic Enzymes
3.2. Improving the Enzyme Activity during Submerged Fermentation
3.3. Isolation of the Aspergillus Clavatus VKPM F-1593 Extracellular Keratinase and Investigation of Some of Its Properties
3.4. Substrate Specificity and Inhibitory Assay of the Aspergillus Clavatus VKPM F-1593 Extracellular Keratinase
3.5. Temperature and pH Effect on the Activity and Stability of the Aspergillus clavatus VKPM F-1593 Extracellular Keratinase
4. Discussion
5. Conclusions
Author Contributions
Funding
Institutional Review Board Statement
Informed Consent Statement
Data Availability Statement
Conflicts of Interest
References
- FAO. World Food and Agriculture—Statistical Yearbook 2021; FAO: Rome, Italy, 2021; pp. 14–18. [Google Scholar]
- Chen, H.; Gao, S.; Li, Y.; Xu, H.J.; Li, W.; Wang, J.; Zhang, Y. Valorization of Livestock Keratin Waste: Application in Agricultural Fields. Int. J. Environ. Res. Public Health 2022, 19, 6681. [Google Scholar] [CrossRef] [PubMed]
- Shavandi, A.; Silva, T.H.; Bekhit, A.A.; Bekhit, A. Keratin: Dissolution, extraction and biomedical application. Biomat. Sci. 2017, 5, 1699–1735. [Google Scholar] [CrossRef] [PubMed]
- Stingone, J.A.; Wing, S. Poultry litter incineration as a source of energy: Reviewing the potential for impacts on environmental health and justice. New Solut. 2011, 21, 27–42. [Google Scholar] [CrossRef]
- Tesfaye, T.; Sithole, B.; Ramjugernath, D.; Chunilall, V. Valorisation of chicken feathers: Characterisation of chemical properties. Waste Manag. 2017, 68, 626–635. [Google Scholar] [CrossRef] [PubMed]
- Ben Hamad Bouhamed, S.; Kechaou, N. Kinetic study of sulphuric acid hydrolysis of protein feathers. Bioprocess Biosys. Eng. 2017, 40, 715–721. [Google Scholar] [CrossRef]
- Chiramba, R.; Charis, G.; Fungura, N.; Danha, G.; Mamvura, T. Production of activated carbon from poultry feathers for waste water treatment. Water Sci. Technol. 2019, 80, 1407–1412. [Google Scholar] [CrossRef]
- Pajarito, B.; Belarmino, A.J.; Calimbas, R.M.; Gonzales, J.R. Graphite Nanoplatelets from Waste Chicken Feathers. Materials 2020, 13, 2109. [Google Scholar] [CrossRef]
- Qiu, J.; Wilkens, C.; Barrett, K.; Meyer, A.S. Microbial enzymes catalyzing keratin degradation: Classification, structure, function. Biotechnol. Adv. 2020, 44, 107607. [Google Scholar] [CrossRef]
- Sypka, M.; Jodłowska, I.; Białkowska, A.M. Keratinases as Versatile Enzymatic Tools for Sustainable Development. Biomolecules 2021, 11, 1900. [Google Scholar] [CrossRef]
- Vidmar, B.; Vodovnik, M. Microbial Keratinases: Enzymes with Promising Biotechnological Applications. Food Technol. Biotechnol. 2018, 56, 312–328. [Google Scholar] [CrossRef]
- Hassan, M.A.; Abol-Fotouh, D.; Omer, A.M.; Tamer, T.M.; Abbas, E. Comprehensive insights into microbial keratinases and their implication in various biotechnological and industrial sectors: A review. Int. J. Biol. Macromol. 2020, 154, 567–583. [Google Scholar] [CrossRef]
- Sharma, C.; Timorshina, S.; Osmolovskiy, A.; Misri, J.; Singh, R. Chicken Feather Waste Valorization into Nutritive Protein Hydrolysate: Role of Novel Thermostable Keratinase from Bacillus pacificus RSA27. Front. Microbiol. 2022, 13, 882902. [Google Scholar] [CrossRef] [PubMed]
- Pei, X.D.; Li, F.; Yue, S.Y.; Huang, X.N.; Gao, T.T.; Jiao, D.Q.; Wang, C.H. Production and characterization of novel thermo- and organic solvent-stable keratinase and aminopeptidase from Pseudomonas aeruginosa 4-3 for effective poultry feather degradation. Environ. Sci. Pollut. Res. Int. 2022. [Google Scholar] [CrossRef] [PubMed]
- Rios, P.; Bezus, B.; Cavalitto, S.; Cavello, I. Production and characterization of a new detergent-stable keratinase expressed by Pedobacter sp. 3.14.7, a novel Antarctic psychrotolerant keratin-degrading bacterium. J. Genet. Eng. Biotechnol. 2022, 20, 81. [Google Scholar] [CrossRef] [PubMed]
- Lien, Y.C.; Lai, S.J.; Lin, C.Y.; Wong, K.P.; Chang, M.S.; Wu, S.H. High-efficiency decomposition of eggshell membrane by a keratinase from Meiothermus taiwanensis. Sci. Rep. 2022, 12, 14684. [Google Scholar] [CrossRef] [PubMed]
- Ma, Q.; Zhang, Y.N.; Zheng, X.; Luan, F.; Han, P.; Zhang, X.; Yin, Y.; Wang, X.; Gao, X. A Newly Isolated Strain Lysobacter brunescens YQ20 and Its Performance on Wool Waste Biodegradation. Front. Microbiol. 2022, 13, 794738. [Google Scholar] [CrossRef] [PubMed]
- Mazotto, A.M.; Cedrola, S.; de Souza, E.P.; Couri, S.; Vermelho, A.B. Enhanced keratinase production by Bacillus subtilis amr using experimental optimization tools to obtain feather protein lysate for industrial applications. 3 Biotech 2022, 12, 90. [Google Scholar] [CrossRef]
- Yahaya, R.; Phang, L.Y.; Normi, Y.M.; Abdullah, J.O.; Ahmad, S.A.; Sabri, S. Feather-Degrading Bacillus cereus HD1: Genomic Analysis and Its Optimization for Keratinase Production and Feather Degradation. Curr. Microbiol. 2022, 79, 166. [Google Scholar] [CrossRef]
- Zhang, R.X.; Wu, Z.W.; Cui, H.Y.; Chai, Y.N.; Hua, C.W.; Wang, P.; Li, L.; Yang, T.Y. Production of surfactant-stable keratinase from Bacillus cereus YQ15 and its application as detergent additive. BMC Biotechnol. 2022, 22, 26. [Google Scholar] [CrossRef]
- Nnolim, N.E.; Udenigwe, C.C.; Okoh, A.I.; Nwodo, U.U. Microbial Keratinase: Next Generation Green Catalyst and Prospective Applications. Front. Microbiol. 2020, 11, 580164. [Google Scholar] [CrossRef]
- Yu, R.J.; Harmon, S.R.; Blank, F. Isolation and purification of an extracellular keratinase of Trichophyton mentagrophytes. J. Bacteriol. 1968, 96, 1435–1436. [Google Scholar] [CrossRef] [PubMed]
- Takiuchi, I.; Higuchi, D.; Sei, Y.; Koga, M. Isolation of an extracellular proteinase (keratinase) from Microsporum canis. Sabouraudia 1982, 20, 281–288. [Google Scholar] [CrossRef] [PubMed]
- Singh, C.J. Characterization of an extracellular keratinase of Trichophyton simii and its role in keratin degradation. Mycopathologia 1997, 137, 13–16. [Google Scholar] [CrossRef] [PubMed]
- Hamaguchi, T.; Morishita, N.; Usui, R.; Takiuchi, I. Characterization of an extracellular keratinase from Microsporum canis. Nihon Ishinkin Gakkai zasshi (Jap. J. Med. Mycol.) 2000, 41, 257–262. [Google Scholar] [CrossRef][Green Version]
- Singh, C.J. Extracellular protease expression in Microsporum gypseum complex, its regulation and keratinolytic potential. Mycoses 2011, 54, e183–e188. [Google Scholar] [CrossRef]
- Sharma, A.; Chandra, S.; Sharma, M. Difference in keratinase activity of dermatophytes at different environmental conditions is an attribute of adaptation to parasitism. Mycoses 2012, 55, 410–415. [Google Scholar] [CrossRef]
- Darah, I.; Nur-Diyana, A.; Nurul-Husna, S.; Jain, K.; Lim, S.H. Microsporum fulvum IBRL SD3: As novel isolate for chicken feathers degradation. Appl. Biochem. Biotechnol. 2013, 171, 1900–1910. [Google Scholar] [CrossRef]
- Możejko, M.; Bohacz, J. Optimization of Conditions for Feather Waste Biodegradation by Geophilic Trichophyton ajelloi Fungal Strains towards Further Agricultural Use. Int. J. Environ. Res. Public Health 2022, 19, 10858. [Google Scholar] [CrossRef]
- De Souza, P.M.; Bittencourt, M.L.; Caprara, C.C.; de Freitas, M.; de Almeida, R.P.; Silveira, D.; Fonseca, Y.M.; Ferreira Filho, E.X.; Pessoa Junior, A.; Magalhães, P.O. A biotechnology perspective of fungal proteases. Braz. J. Microbiol. 2015, 46, 337–346. [Google Scholar] [CrossRef]
- Osmolovskiy, A.A.; Popova, E.A.; Kreyer, V.G.; Baranova, N.A.; Egorov, N.S. Vermiculite as a new carrier for extracellular protease production by Aspergillus spp. under solid-state fermentation. Biotechnol. Rep. 2020, 29, e00576. [Google Scholar] [CrossRef]
- Kurtzman, C.P.; Robnett, C.J. Identification and phylogeny of ascomycetous yeasts from analysis of nuclear large subunit (26S) ribosomal DNA partial sequences. Antonie van Leeuwenhoek 1998, 73, 331–371. [Google Scholar] [CrossRef] [PubMed]
- Glass, N.L.; Donaldson, G.C. Development of primer sets designed for use with the PCR to amplify conserved genes from filamentous ascomycetes. Appl. Environ. Microbiol. 1995, 61, 1323–1330. [Google Scholar] [CrossRef] [PubMed]
- Kumar, S.; Stecher, G.; Li, M.; Knyaz, C.; Tamura, K. MEGA X: Molecular Evolutionary Genetics Analysis across Computing Platforms. Mol. Biol. Evol. 2018, 35, 1547–1549. [Google Scholar] [CrossRef] [PubMed]
- Osmolovskiy, A.A.; Schmidt, L.; Orekhova, A.V.; Komarevtsev, S.K.; Kreyer, V.G.; Shabunin, S.V.; Egorov, N.S. Action of Extracellular Proteases of Aspergillus flavus and Aspergillus ochraceus Micromycetes on Plasma Hemostasis Proteins. Life 2021, 11, 782. [Google Scholar] [CrossRef] [PubMed]
- Laemmli, U.K. Cleavage of structural proteins during the assembly of the head of bacteriophage T4. Nature 1970, 227, 680–685. [Google Scholar] [CrossRef] [PubMed]
- Thornton, D.J.; Carlstedt, I.; Sheehan, J.K. Identification of glycoproteins on nitrocellulose membranes and gels. Mol. Biotechnol. 1996, 5, 171–176. [Google Scholar] [CrossRef]
- Varga, J.; Due, M.; Frisvad, J.C.; Samson, R.A. Taxonomic revision of Aspergillus section Clavati based on molecular, morphological and physiological data. Stud. Mycol. 2007, 59, 89–106. [Google Scholar] [CrossRef]
- El-Gendy, M.M. Keratinase production by endophytic Penicillium spp. Morsy1 under solid-state fermentation using rice straw. Appl. Biochem. Biotechnol. 2010, 162, 780–794. [Google Scholar] [CrossRef]
- Anitha, T.S.; Palanivelu, P. Purification and characterization of an extracellular keratinolytic protease from a new isolate of Aspergillus parasiticus. Protein Express. Purif. 2013, 88, 214–220. [Google Scholar] [CrossRef]
- Cavello, I.A.; Chesini, M.; Hours, R.A.; Cavalitto, S.F. Study of the production of alkaline keratinases in submerged cultures as an alternative for solid waste treatment generated in leather technology. J. Microbiol. Biotechnol. 2013, 23, 1004–1014. [Google Scholar] [CrossRef]
- de Oliveira, C.C.; de Souza, A.; de Castro, R. Bioconversion of Chicken Feather Meal by Aspergillus niger: Simultaneous Enzymes Production Using a Cost-Effective Feedstock Under Solid State Fermentation. Indian J. Microbiol. 2019, 59, 209–216. [Google Scholar] [CrossRef] [PubMed]
- Preczeski, K.P.; Dalastra, C.; Czapela, F.F.; Kubeneck, S.; Scapini, T.; Camargo, A.F.; Zanivan, J.; Bonatto, C.; Stefanski, F.S.; Venturin, B.; et al. Fusarium oxysporum and Aspergillus sp. as Keratinase Producers Using Swine Hair from Agroindustrial Residues. Front. Bioeng. Biotechnol. 2020, 8, 71. [Google Scholar] [CrossRef] [PubMed]
- Alwakeel, S.S.; Ameen, F.; Al Gwaiz, H.; Sonbol, H.; Alghamdi, S.; Moharram, A.M.; Al-Bedak, O.A. Keratinases Produced by Aspergillus stelliformis, Aspergillus sydowii, and Fusarium brachygibbosum Isolated from Human Hair: Yield and Activity. J. Fungi 2021, 7, 471. [Google Scholar] [CrossRef] [PubMed]
- Kothary, M.H.; Chase, T., Jr.; Macmillan, J.D. Correlation of elastase production by some strains of Aspergillus fumigatus with ability to cause pulmonary invasive aspergillosis in mice. Infect. Immun. 1984, 43, 320–325. [Google Scholar] [CrossRef] [PubMed]
- Tamura, Y.; Suzuki, S.; Sawada, T. Role of elastase as a virulence factor in experimental Pseudomonas aeruginosa infection in mice. Microb. Pathogenesis 1992, 12, 237–244. [Google Scholar] [CrossRef]
- Khosravi, A.R.; Mahdavi Omran, S.; Shokri, H.; Lotfi, A.; Moosavi, Z. Importance of elastase production in development of invasive aspergillosis. J. Mycol. Med. 2012, 22, 167–172. [Google Scholar] [CrossRef] [PubMed]
- Cadena, J.; Thompson, G.R., 3rd; Patterson, T.F. Aspergillosis: Epidemiology, Diagnosis, and Treatment. Infect. Dis. Clin. 2021, 35, 415–434. [Google Scholar] [CrossRef]
- Cairns, T.C.; Barthel, L.; Meyer, V. Something old, something new: Challenges and developments in Aspergillus niger biotechnology. Essays Biochem. 2021, 65, 213–224. [Google Scholar] [CrossRef]
- Füting, P.; Barthel, L.; Cairns, T.C.; Briesen, H.; Schmideder, S. Filamentous fungal applications in biotechnology: A combined bibliometric and patentometric assessment. Fung. Biol. Biotechnol. 2021, 8, 23. [Google Scholar] [CrossRef]
- Qiu, J.; Barrett, K.; Wilkens, C.; Meyer, A.S. Bioinformatics based discovery of new keratinases in protease family M36. New Biotechnol. 2022, 68, 19–27. [Google Scholar] [CrossRef]
- Kim, J.D. Purification and Characterization of a Keratinase from a Feather-Degrading Fungus, Aspergillus flavus Strain K-03. Mycobiology 2007, 35, 219–225. [Google Scholar] [CrossRef] [PubMed]
- Paul, T.; Das, A.; Mandal, A.; Halder, S.K.; DasMohapatra, P.K.; Pati, B.R.; Mondal, K.C. Production and purification of keratinase using chicken feather bioconversion by a newly isolated Aspergillus fumigatus TKF1: Detection of valuable metabolites. Biomass Conv. Bioref. 2014, 4, 137–148. [Google Scholar] [CrossRef]
- Mazotto, A.; Couri, S.; Damaso, M.; Vermelho, A. Degradation of feather waste by Aspergillus niger keratinases: Comparison of submerged and solid-state fermentation. Int. Biodeter. Biodegrad. 2013, 85, 189–195. [Google Scholar] [CrossRef]
- Farag, A.M.; Hassan, M.A. Purification, characterization and immobilization of a keratinase from Aspergillus oryzae. Enzyme Microbial Technol. 2004, 34, 85–93. [Google Scholar] [CrossRef]
- Sousa, M.A.; Souza, O.C.; Maciel, M.H.; Cruz, R.C.; Rego, M.; Magalhães, O.M.; Pessoa-Júnior, A.; Porto, A.L.; Souza-Motta, C.M. Keratinolytic potential of fungi isolated from soil preserved at the Micoteca URM. Eur. J. Biotechnol. Biosci. 2015, 3, 10–15. [Google Scholar]
- Da Silva, O.S.; de Almeida, E.M.; de Melo, A.; Porto, T.S. Purification and characterization of a novel extracellular serine-protease with collagenolytic activity from Aspergillus tamarii URM4634. Int. J. Biol. Macromol. 2018, 117, 1081–1088. [Google Scholar] [CrossRef]

| Components | Medium 1, % | Medium 2, % | Medium 3, % |
|---|---|---|---|
| K2HPO4 | 0.1 | ||
| MgSO4 × 7H2O | 0.05 | ||
| KCl | 0.025 | ||
| NaCl | 0.025 | ||
| FeSO4 × 7H2O | 0.001 | ||
| Glucose | 3.0 | ||
| Keratin | 0.5 | 0.5 | – |
| NaNO3 | – | 0.3 | 0.3 |
| Strain | LSU rRNA | benA |
|---|---|---|
| Aspergillus clavatus VKPM F-1593 (A16) | OK559552.1 | OP254188 |
| Aspergillus clavatus CBS 513.65 | NG_070579.1 | EU076340.1 |
| Aspergillus clavatus CBS 514.65 | MH870335.1 | EU076339.1 |
| Aspergillus clavatus NRRL 2254 | U28392.1 | EF669809.1 |
| Aspergillus clavatus NRRL 1 | U28390.1 | EF669802.1 |
| Aspergillus clavatonanicus NRRL 4741 | U28397.1 | EF669842.1 |
| Aspergillus felis CBS 130245 | NG_070010.1 | MN969363.1 |
| Aspergillus fumigatus CBS 386.75 | MH872681.1 | AY685168.1 |
| Aspergillus giganteus NRRL 10 | U28395.1 | EF669789.1 |
| Aspergillus giganteus CBS 101.64 | MH869999.1 | EU076337.1 |
| Aspergillus giganteus CBS 117.56 | MH869070.1 | EU076336.1 |
| Aspergillus giganteus CBS 526.65 | NG_069722.1 | EU076331.1 |
| Aspergillus longivesica NRRL 5215 | U28400.1 | EF669847.1 |
| Aspergillus niger ATCC 16888 | NG_055744.1 | FJ608394.1 |
| Aspergillus rhizopodus CBS 450.75 | MH872694.1 | EU076327.1 |
| Neocarpenteles acanthosporus CBS 558.71 | AB003809.1 | EU076322.1 |
| Fungi | EIker./EIcas. | EIgel./EIcas. | EIfibr./EIcas. | EIel./EIcas. |
|---|---|---|---|---|
| A. amstelodami A6 | 1.26 | 0.93 | 1.28 | 0.70 |
| A. clavatus VKPM F-1593 | 0.71 | 1.13 | 0.75 | 0.58 |
| A. ochraceus 247 | 0.97 | 1.37 | 1.05 | 0.90 |
| C. sphaerospermum 1779 | 0.61 | 1.18 | 0.72 | 0.67 |
| Producers | Molecular Weight | pH-Optimum (Stability) | T-Optimum (Stability), °C | Type of Proteasse | References |
|---|---|---|---|---|---|
| A. clavatus | 44 | 8 | 45 | metallo | [51] |
| 27 | 8 (4–10) | 50 (25–40) | serine | Data obtained in this study | |
| A. flavus | 31 | 8 (7–10) | 45 (30–70) | serine | [52] |
| A. fumigatus | 24 | 6 (4–8) | 50 | – | [53] |
| A. niger | 60 | – | – | serine | [54] |
| 130 | – | – | serine | [54] | |
| A. oryzae | 60 | 8 | 50 | metallo | [55] |
| A. parasiticus | 36 | 7 | 50 | serine | [40] |
| A. stelliformis | – | 8 | 50 | – | [44] |
| A. sulphureus | – | 10 (6.5–9) | 35 (25–60) | – | [56] |
| A. sydowii | – | 8 | 50 | – | [44] |
| A. tamarii | – | 8 (5–11) | 40 (10–40) | serine | [57] |
Publisher’s Note: MDPI stays neutral with regard to jurisdictional claims in published maps and institutional affiliations. |
© 2022 by the authors. Licensee MDPI, Basel, Switzerland. This article is an open access article distributed under the terms and conditions of the Creative Commons Attribution (CC BY) license (https://creativecommons.org/licenses/by/4.0/).
Share and Cite
Timorshina, S.; Popova, E.; Kreyer, V.; Baranova, N.; Osmolovskiy, A. Keratinolytic Properties of Aspergillus clavatus Promising for Biodegradation. Int. J. Environ. Res. Public Health 2022, 19, 13939. https://doi.org/10.3390/ijerph192113939
Timorshina S, Popova E, Kreyer V, Baranova N, Osmolovskiy A. Keratinolytic Properties of Aspergillus clavatus Promising for Biodegradation. International Journal of Environmental Research and Public Health. 2022; 19(21):13939. https://doi.org/10.3390/ijerph192113939
Chicago/Turabian StyleTimorshina, Svetlana, Elizaveta Popova, Valeriana Kreyer, Nina Baranova, and Alexander Osmolovskiy. 2022. "Keratinolytic Properties of Aspergillus clavatus Promising for Biodegradation" International Journal of Environmental Research and Public Health 19, no. 21: 13939. https://doi.org/10.3390/ijerph192113939
APA StyleTimorshina, S., Popova, E., Kreyer, V., Baranova, N., & Osmolovskiy, A. (2022). Keratinolytic Properties of Aspergillus clavatus Promising for Biodegradation. International Journal of Environmental Research and Public Health, 19(21), 13939. https://doi.org/10.3390/ijerph192113939

